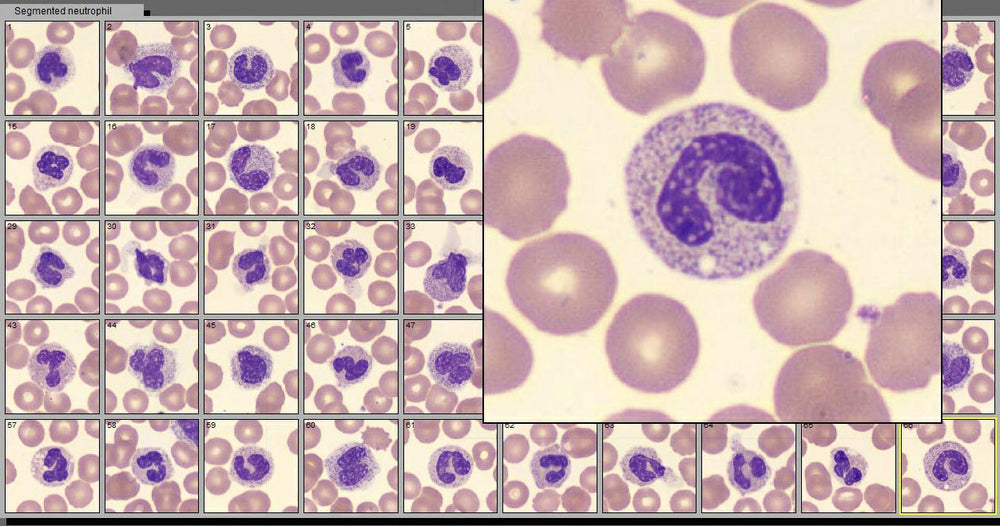

Solución de nitrato de plata, 5%
Precio habitual
$113.67
$113.67
Precio habitual
Precio de oferta
$113.67
$113.67
Guardar $-113.67
/
- Pagos seguros
Componente utilizado en el Grocott Methenamine Silver Stain Kit de Volu-Sol.